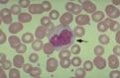
Miniatura de la versión del 10:10 20 nov 2011

Archivo:Monoff.jpeg
Monoff.jpeg (121 × 79 píxeles; tamaño de archivo: 3 KB; tipo MIME: image/jpeg)
Sumario
Estado de copyright:
Fuente:
Historial del archivo
Haz clic sobre una fecha/hora para ver el archivo a esa fecha.
| Fecha y hora | Miniatura | Dimensiones | Colaborador | Comentario | |
|---|---|---|---|---|---|
| actual | 10:10 20 nov 2011 | | 121 × 79 (3 KB) | Sahily02055jc (discusión | contribuciones) |
- No puedes sobrescribir este archivo.
Usos del archivo
La siguiente página enlaza a este archivo:
